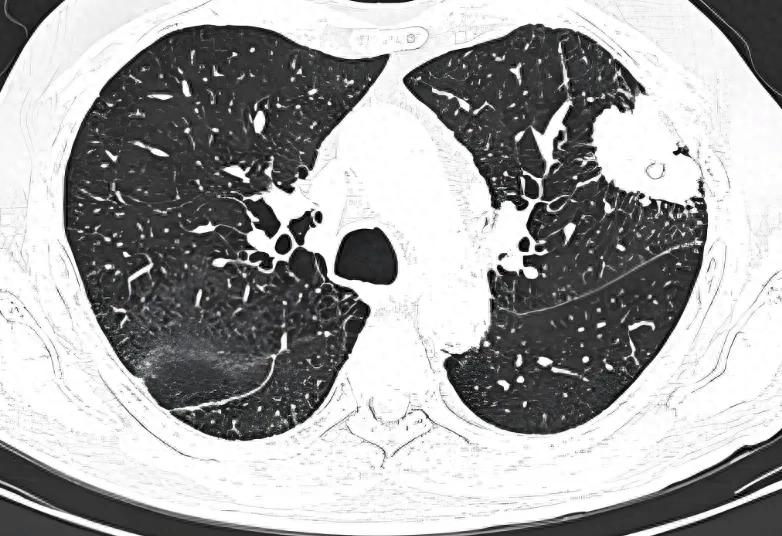

肺鳞癌术后免疫治疗与复发率
肺鳞癌术后联合免疫治疗的复发率数据在近年的临床研究中取得了显著进展,尤其是新辅助(术前)和围术期(术前 + 术后)治疗模式的突破。以下是结合最新研究(截至 2025 年 6 月)的综合分析:
一、新辅助免疫治疗的长期获益
1. CheckMate 816 研究(III 期)
5 年随访数据:
术前使用纳武利尤单抗(PD-1 抑制剂)联合化疗的患者,5 年总生存率(OS)为65%,显著高于单纯化疗组的 55%。
病理完全缓解(pCR)患者:术后 5 年 OS 率高达95%,无事件生存率(EFS)达88%,复发风险降低近 90%(HR=0.11)。
肺鳞癌亚组:鳞癌患者的 pCR 率提升更显著(约 24%),且术后复发风险降低幅度大于腺癌。

2. Neotorch 研究(III 期)
特瑞普利单抗联合化疗的围术期治疗(新辅助 + 辅助)显示,鳞癌患者的主要病理缓解率(MPR)达 76.7%,pCR 率达 50%,R0 切除率 93.3%,显著降低术后复发风险。
真实案例:III 期肺鳞癌患者通过围术期免疫治疗达到 pCR,术后两年无复发。

二、术后辅助免疫治疗的关键数据
1. IMpower010 研究(III 期)
PD-L1 高表达(TC≥50%)患者:
术后使用阿替利珠单抗(PD-L1 抑制剂)辅助治疗,3 年无病生存率(DFS)为 73.8%,显著高于对照组的 48.6%;5 年 OS 率达84.8%,复发风险降低约 50%。
亚洲人群亚组:
PD-L1 TC≥1% 的 II-IIIA 期鳞癌患者,阿替利珠单抗组的中位 DFS 为 42.3 个月,显著优于对照组的 31.4 个月(HR=0.63)。

2. KEYNOTE-091 研究(III 期)
帕博利珠单抗(PD-1 抑制剂)辅助治疗显著延长全人群 DFS(HR=0.76),但 PD-L1≥50% 亚组未达统计学意义。尽管未单独披露鳞癌数据,但亚组分析显示鳞癌患者可能从免疫治疗中获益。
3. 真实世界研究
中国真实世界数据显示,肺鳞癌患者接受免疫联合化疗后,中位无进展生存期(PFS)和总生存期(OS)显著延长,且 PD-L1 高表达或 TMB 高的患者获益更明显。
高龄患者(≥70 岁)接受免疫联合化疗的疗效与低龄组相似,不良反应可控。

三、影响复发率的核心因素
病理缓解程度
pCR 患者:术后复发风险极低,5 年 OS 率可达 95%,接近临床治愈。
非 pCR 患者:仍需术后辅助治疗,尤其是 PD-L1 阴性或 ctDNA 未清除者,复发风险较高(5 年 OS 率约 56%)。

生物标志物
PD-L1 表达:高表达(TC≥50%)患者术后免疫治疗获益更显著,3 年 DFS 率提升约 25%。
TMB:高 TMB 患者联合治疗的 PFS 显著延长,但需结合 PD-L1 表达综合评估。
ctDNA:新辅助治疗后 ctDNA 清除者复发风险降低,5 年 OS 率显著提高。

治疗模式
围术期模式:新辅助 + 辅助免疫治疗(如 CheckMate 816 的 “3 周期新辅助 + 术后辅助”)较单纯新辅助或术后辅助更显著降低复发风险(EFS HR=0.61)。
分期:III 期患者术后复发风险高于 II 期,但免疫治疗可显著缩小差距(III 期患者 5 年 OS 率提升 10%)。

四、临床实践建议
推荐人群
可切除 II-IIIA 期肺鳞癌:优先考虑新辅助免疫联合化疗,术后根据病理结果决定是否继续辅助治疗。
PD-L1 高表达(TC≥50%)或 TMB 高:术后辅助免疫治疗(如阿替利珠单抗、帕博利珠单抗)可显著降低复发风险。
术后残留高危因素:如淋巴结转移(N1-N2)、低分化、脉管侵犯等,需联合免疫治疗强化预防。

方案选择
新辅助治疗:3 周期免疫联合化疗(如纳武利尤单抗 + 铂类)是目前标准方案,pCR 率可达 20%-30%。
术后辅助治疗:PD-L1 高表达者优先选择阿替利珠单抗;PD-L1 阴性或未知者可考虑帕博利珠单抗或特瑞普利单抗。
维持治疗:围术期治疗后建议免疫单药维持 1 年,以进一步巩固疗效。

监测与随访
ctDNA 检测:术后定期监测 ctDNA,若持续阴性提示复发风险低;若阳性需及时干预。
影像学检查:术后前 2 年每 3-6 个月行胸部 CT,之后每 6-12 个月一次,结合 PET-CT 排查转移。

*如有身体不适请及时就医。(注明:图片源于网络,如有侵权请联系删除)